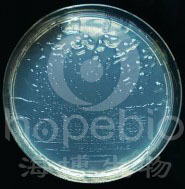

海博微信公众号
海博微信公众号
 海博天猫旗舰店
海博天猫旗舰店


 海博微信公众号
海博微信公众号
 海博天猫旗舰店
海博天猫旗舰店




一、培养基用途:
用于利用硅酸盐的微生物的分离培养。
二、培养基成分及使用方法:
1.培养基成分
|
成分 |
含量(g/L) |
|
蔗糖 |
5.0 |
|
硫酸镁 |
0.5 |
|
硫酸钙 |
0.1 |
|
磷酸氢二钠 |
2.0 |
|
氯化铁 |
0.005 |
|
玻璃粉 |
1.0 |
|
琼脂 |
15.0 |
|
pH 7.0±0.2 25℃ |
|
2.使用方法
称取本品23.6g,加热溶解于1000ml蒸馏水中,分装。116℃高压灭菌30分钟。
三、原理:
蔗糖为可发酵糖类;硫酸镁、硫酸钙、氯化铁提供细菌生长所必需的离子;硅酸盐细菌能够分解硅铝酸盐矿物,将矿物态钾转变为可溶性钾为菌体自身或植物所利用;琼脂是培养基凝固剂。
四、实验结果:
1、按使用方法制备培养基,接种以下质控菌株,在36±1℃需氧培养48-96小时。
|
质控菌株 |
菌株编号 |
接种量(CFU) |
生长情况(回收率) |
其他特征 |
|
胶质芽孢杆菌 |
/ |
/ |
+++ |
无色隆起,胶质粘稠,边缘整齐的透明菌落 |
2、胶质芽孢杆菌在培养基中的生长情况如下图所示:
硅酸盐细菌培养基微生物质控结果
五、注意事项
本培养基仅为细菌鉴定的一部分,需做其他补充实验。
上一篇:OGY琼脂原理及实验现象



